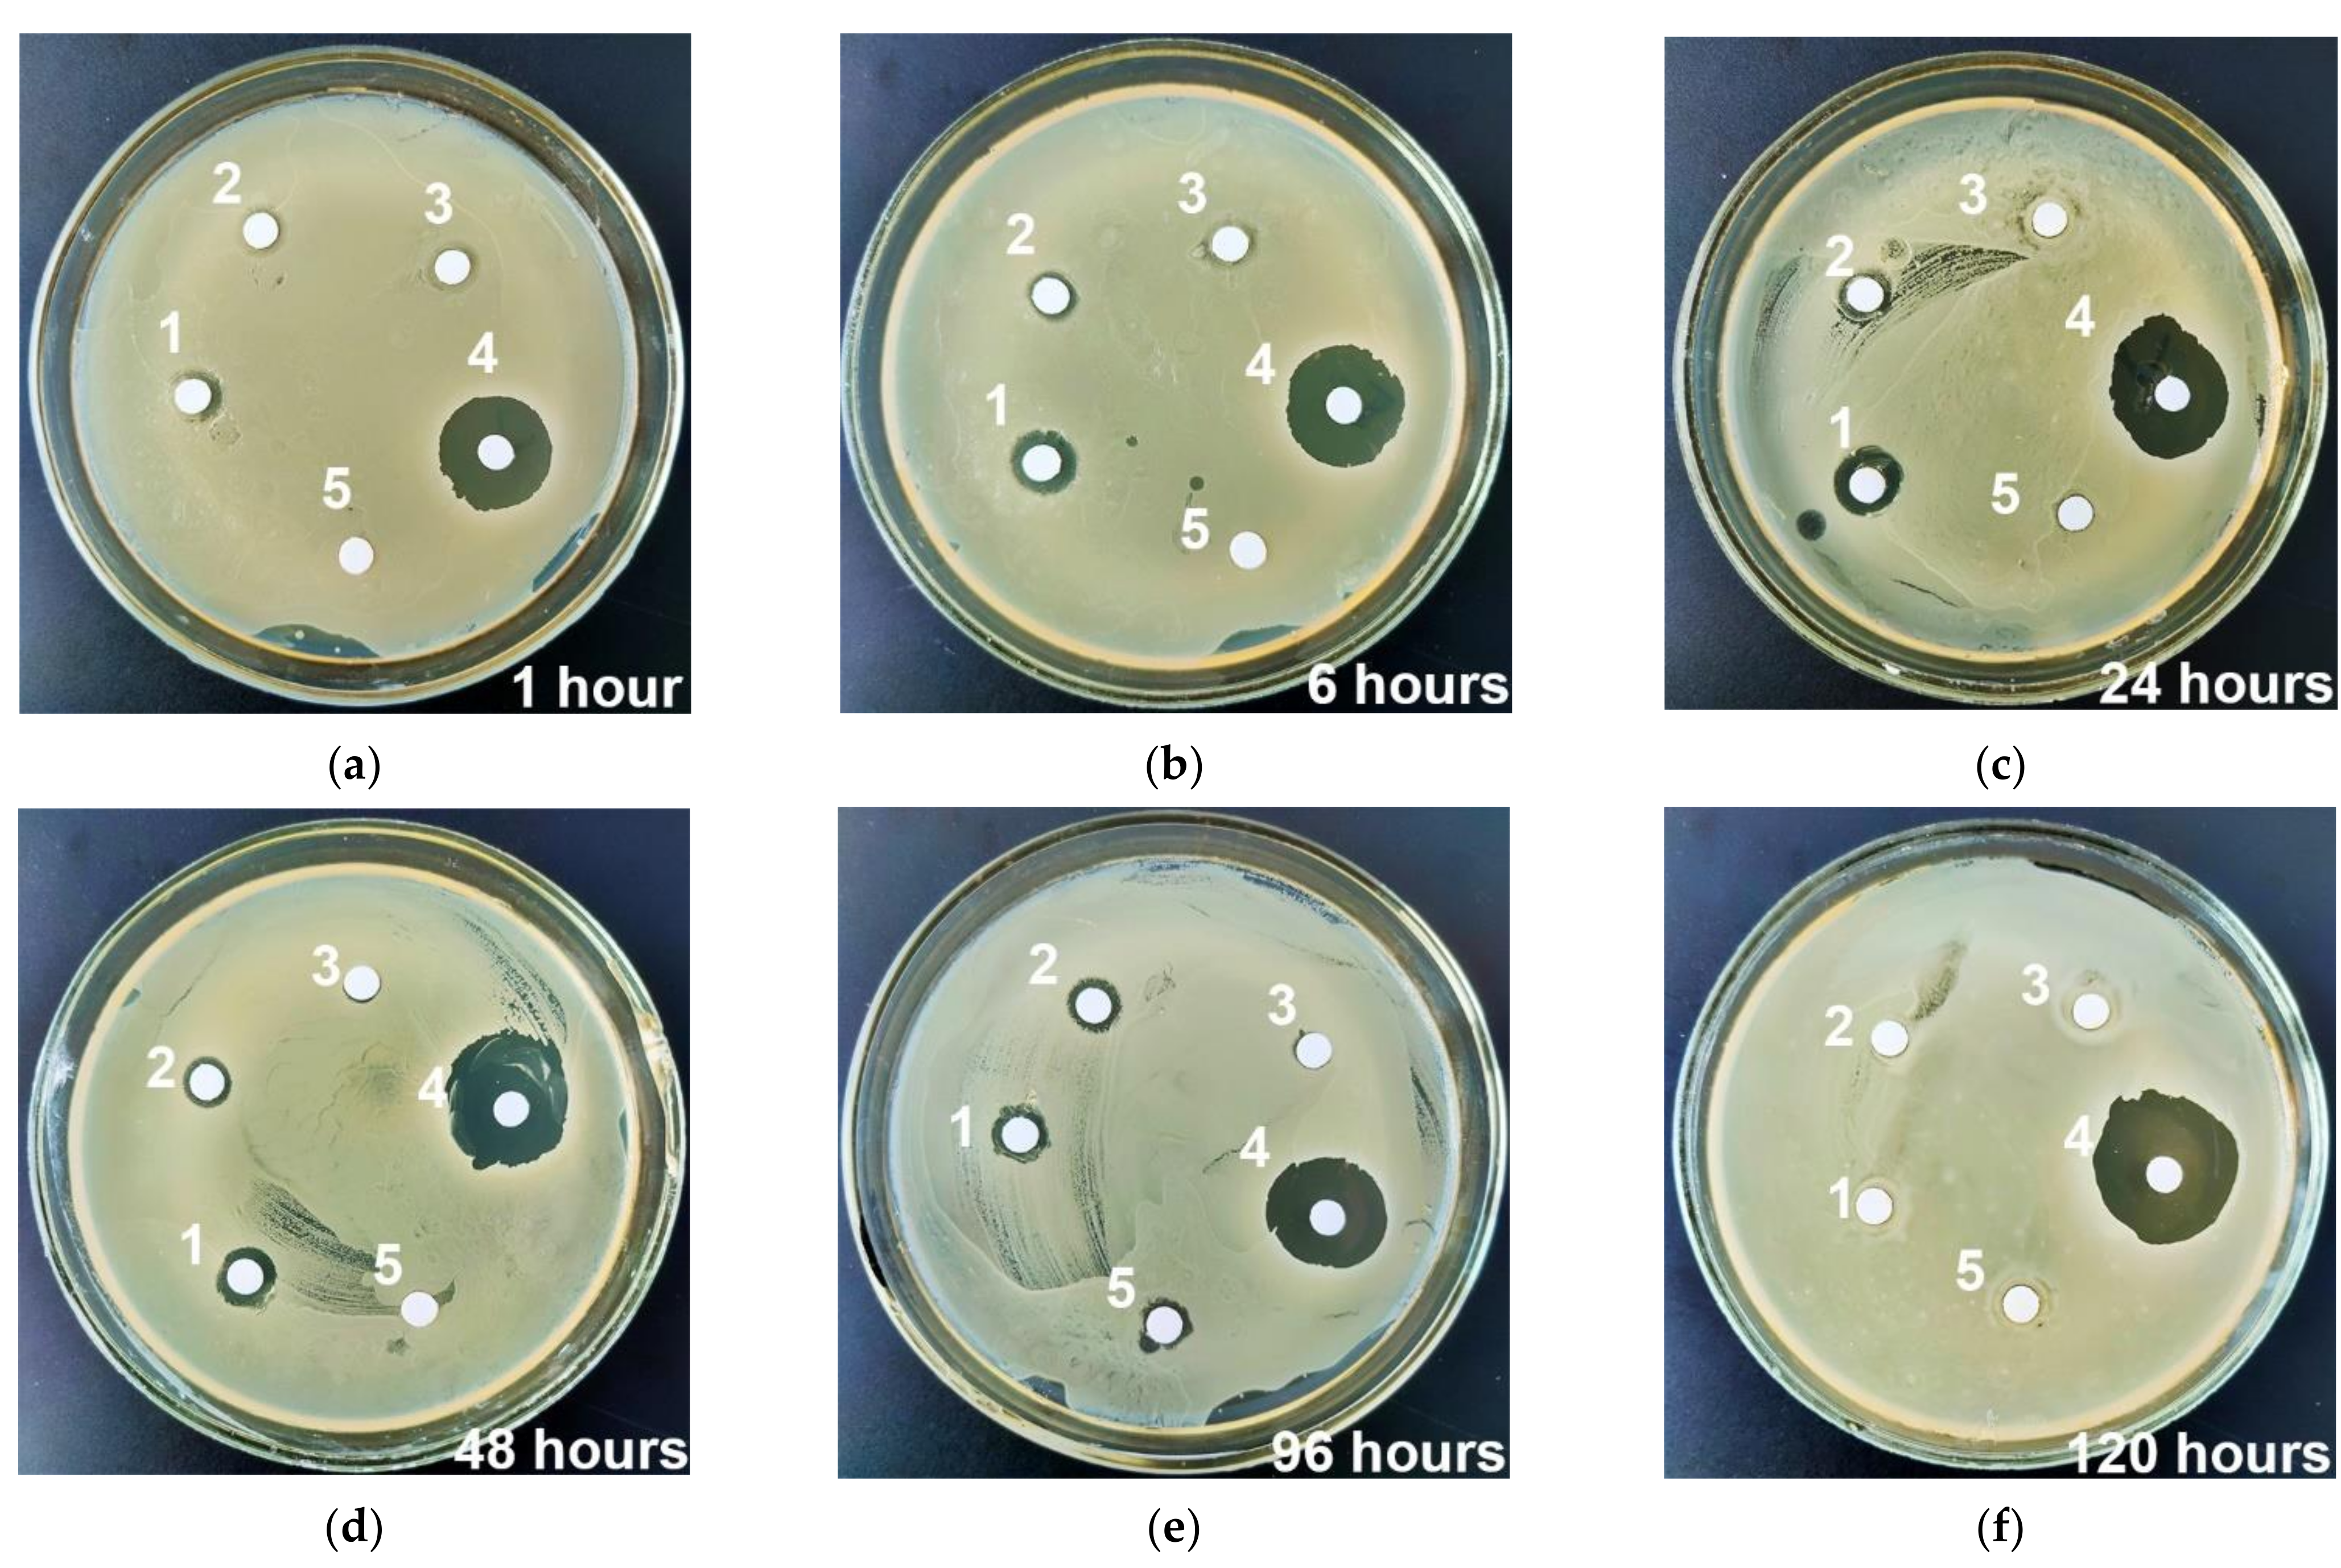
Materials 15 04643 g012 Materials 15 04643 g012

UMAOH Calcium Phosphate Coatings Designed for Drug Delivery: Vancomycin, 5-Fluorouracil, Interferon α-2b Case
Abstract
1. Introduction
2. Materials and Methods
2.1. Pre- and Treatment Procedures
2.2. Experimental Techniques
2.3. Drugs’ Loading and Desorption Studies
2.3.1. Concentration of IFNα in Commercially Available Drug Reaferon EC
2.3.2. Enzyme-Linked Immunosorbent Assay of IFNα Releasing UMAOH CaP Coatings Delivery System
2.4. Cytotoxicity In Vitro
2.5. Antibacterial Assay
2.6. Statistical Analysis
3. Results and Discussion
3.1. Production of UMAO Coatings and Their Characterization
3.2. Drugs Immobilization and Desorption Kinetics
3.3. Cytotoxicity Test In Vitro
3.4. Antibacterial Studies
4. Conclusions
Author Contributions
Funding
Institutional Review Board Statement
Informed Consent Statement
Acknowledgments
Conflicts of Interest
References
- Chen, Y.-C.; Gad, S.F.; Chobisa, D.; Li, Y.; Yeo, Y. Local Drug Delivery Systems for Inflammatory Diseases: Status Quo, Challenges, and Opportunities. J. Control. Release 2021, 330, 438–460. [Google Scholar] [CrossRef] [PubMed]
- Barik, A.; Chakravorty, N. Targeted Drug Delivery from Titanium Implants: A Review of Challenges and Approaches. In Trends in Biomedical Research; Pokorski, M., Ed.; Advances in Experimental Medicine and Biology; Springer International Publishing: Cham, Germany, 2019; Volume 1251, pp. 1–17. ISBN 978-3-030-41218-0. [Google Scholar]
- Geraili, A.; Xing, M.; Mequanint, K. Design and Fabrication of Drug-delivery Systems toward Adjustable Release Profiles for Personalized Treatment. VIEW 2021, 2, 20200126. [Google Scholar] [CrossRef]
- Jayasree, A.; Ivanovski, S.; Gulati, K. ON or OFF: Triggered Therapies from Anodized Nano-Engineered Titanium Implants. J. Control. Release 2021, 333, 521–535. [Google Scholar] [CrossRef] [PubMed]
- Ho, N.T.; Siggel, M.; Camacho, K.V.; Bhaskara, R.M.; Hicks, J.M.; Yao, Y.-C.; Zhang, Y.; Köfinger, J.; Hummer, G.; Noy, A. Membrane Fusion and Drug Delivery with Carbon Nanotube Porins. Proc. Natl. Acad. Sci. USA 2021, 118, e2016974118. [Google Scholar] [CrossRef]
- Salama, A. Recent Progress in Preparation and Applications of Chitosan/Calcium Phosphate Composite Materials. Int. J. Biol. Macromol. 2021, 178, 240–252. [Google Scholar] [CrossRef]
- Vidal, E.; Guillem-Marti, J.; Ginebra, M.-P.; Combes, C.; Rupérez, E.; Rodriguez, D. Multifunctional Homogeneous Calcium Phosphate Coatings: Toward Antibacterial and Cell Adhesive Titanium Scaffolds. Surf. Coat. Technol. 2021, 405, 126557. [Google Scholar] [CrossRef]
- Sokolova, V.; Epple, M. Biological and Medical Applications of Calcium Phosphate Nanoparticles. Chem. Eur. J. 2021, 27, 7471–7488. [Google Scholar] [CrossRef]
- Uskoković, V.; Uskoković, D.P. Nanosized Hydroxyapatite and Other Calcium Phosphates: Chemistry of Formation and Application as Drug and Gene Delivery Agents. J. Biomed. Mater. Res. B 2011, 96, 152–191. [Google Scholar] [CrossRef]
- Liu, Z.; Liu, X.; Ramakrishna, S. Surface Engineering of Biomaterials in Orthopedic and Dental Implants: Strategies to Improve Osteointegration, Bacteriostatic and Bactericidal Activities. Biotechnol. J. 2021, 16, 2000116. [Google Scholar] [CrossRef]
- Hayashi, K.; Tsuchiya, A.; Shimabukuro, M.; Ishikawa, K. Multiscale Porous Scaffolds Constructed of Carbonate Apatite Honeycomb Granules for Bone Regeneration. Mater. Des. 2022, 215, 110468. [Google Scholar] [CrossRef]
- Hurle, K.; Oliveira, J.M.; Reis, R.L.; Pina, S.; Goetz-Neunhoeffer, F. Ion-Doped Brushite Cements for Bone Regeneration. Acta Biomater. 2021, 123, 51–71. [Google Scholar] [CrossRef] [PubMed]
- Prosolov, K.A.; Khimich, M.A.; Rau, J.V.; Lychagin, D.V.; Sharkeev, Y.P. Influence of Oblique Angle Deposition on Cu-Substituted Hydroxyapatite Nano-Roughness and Morphology. Surf. Coat. Technol. 2020, 394, 125883. [Google Scholar] [CrossRef]
- Prosolov, K.A.; Mitrichenko, D.V.; Prosolov, A.B.; Nikolaeva, O.O.; Lastovka, V.V.; Belyavskaya, O.A.; Chebodaeva, V.A.; Glukhov, I.A.; Litvinova, L.S.; Shupletsova, V.V.; et al. Zn-Doped CaP-Based Coatings on Ti–6Al–4V and Ti–6Al–7Nb Alloys Prepared by Magnetron Sputtering: Controllable Biodegradation, Bacteriostatic, and Osteogenic Activities. Coatings 2021, 11, 809. [Google Scholar] [CrossRef]
- Zakhireh, S.; Adibkia, K.; Beygi-Khosrowshahi, Y.; Barzegar-Jalali, M. Osteogenesis Promotion of Selenium-Doped Hydroxyapatite for Application as Bone Scaffold. Biol. Trace Elem. Res. 2021, 199, 1802–1811. [Google Scholar] [CrossRef]
- Acheson, J.G.; Robinson, L.; McKillop, S.; Wilson, S.; McIvor, M.J.; Meenan, B.J.; Boyd, A.R. TOFSIMS and XPS Characterisation of Strontium in Amorphous Calcium Phosphate Sputter Deposited Coatings. Mater. Charact. 2021, 171, 110739. [Google Scholar] [CrossRef]
- Patntirapong, S.; Habibovic, P.; Hauschka, P.V. Effects of Soluble Cobalt and Cobalt Incorporated into Calcium Phosphate Layers on Osteoclast Differentiation and Activation. Biomaterials 2009, 30, 548–555. [Google Scholar] [CrossRef]
- Ginebra, M.P.; Traykova, T.; Planell, J.A. Calcium Phosphate Cements as Bone Drug Delivery Systems: A Review. J. Control. Release 2006, 113, 102–110. [Google Scholar] [CrossRef]
- Zhang, Q.; Zhao, D.; Zhang, X.-Z.; Cheng, S.-X.; Zhuo, R.-X. Calcium Phosphate/DNA Co-Precipitates Encapsulated Fast-Degrading Polymer Films for Substrate-Mediated Gene Delivery. J. Biomed. Mater. Res. B 2009, 91, 172–180. [Google Scholar] [CrossRef]
- Wang, H.; Lee, J.-K.; Moursi, A.; Lannutti, J.J. Ca/P Ratio Effects on the Degradation of Hydroxyapatitein Vitro. J. Biomed. Mater. Res. A 2003, 67, 599–608. [Google Scholar] [CrossRef]
- Khalifehzadeh, R.; Arami, H. Biodegradable Calcium Phosphate Nanoparticles for Cancer Therapy. Adv. Colloid Interface Sci. 2020, 279, 102157. [Google Scholar] [CrossRef]
- Lodoso-Torrecilla, I.; van den Beucken, J.J.J.P.; Jansen, J.A. Calcium Phosphate Cements: Optimization toward Biodegradability. Acta Biomater. 2021, 119, 1–12. [Google Scholar] [CrossRef] [PubMed]
- Rousselle, A.-V.; Heymann, D. Osteoclastic Acidification Pathways during Bone Resorption. Bone 2002, 30, 533–540. [Google Scholar] [CrossRef]
- Huang, D.; He, B.; Mi, P. Calcium Phosphate Nanocarriers for Drug Delivery to Tumors: Imaging, Therapy and Theranostics. Biomater. Sci. 2019, 7, 3942–3960. [Google Scholar] [CrossRef] [PubMed]
- Trofimov, A.; Ivanova, A.; Zyuzin, M.; Timin, A. Porous Inorganic Carriers Based on Silica, Calcium Carbonate and Calcium Phosphate for Controlled/Modulated Drug Delivery: Fresh Outlook and Future Perspectives. Pharmaceutics 2018, 10, 167. [Google Scholar] [CrossRef] [PubMed]
- Sethy, C.; Kundu, C.N. 5-Fluorouracil (5-FU) Resistance and the New Strategy to Enhance the Sensitivity against Cancer: Implication of DNA Repair Inhibition. Biomed. Pharmacother. 2021, 137, 111285. [Google Scholar] [CrossRef]
- Srivastava, S.; Gupta, S.; Mohammad, S.; Ahmad, I. Development of α-Tocopherol Surface-Modified Targeted Delivery of 5-Fluorouracil-Loaded Poly-D, L-Lactic-Co-Glycolic Acid Nanoparticles against Oral Squamous Cell Carcinoma. J. Can. Res. Ther. 2019, 15, 480. [Google Scholar] [CrossRef]
- Uchida, K.; Sugo, K.; Nakajima, T.; Nakawaki, M.; Takano, S.; Nagura, N.; Takaso, M.; Urabe, K. In Vivo Release of Vancomycin from Calcium Phosphate Cement. BioMed Res. Int. 2018, 2018, 4560647. [Google Scholar] [CrossRef]
- Morçöl, T.; Weidner, J.M.; Mehta, A.; Bell, S.J.D.; Block, T. Calcium Phosphate Particles as Pulmonary Delivery System for Interferon-α in Mice. AAPS PharmSciTech 2018, 19, 395–412. [Google Scholar] [CrossRef]
- Kamei, N.; Morishita, M.; Chiba, H.; Kavimandan, N.J.; Peppas, N.A.; Takayama, K. Complexation Hydrogels for Intestinal Delivery of Interferon β and Calcitonin. J. Control. Release 2009, 134, 98–102. [Google Scholar] [CrossRef]
- Qadir, M.; Li, Y.; Munir, K.; Wen, C. Calcium Phosphate-Based Composite Coating by Micro-Arc Oxidation (MAO) for Biomedical Application: A Review. Crit. Rev. Solid State Mater. Sci. 2018, 43, 392–416. [Google Scholar] [CrossRef]
- Simchen, F.; Sieber, M.; Kopp, A.; Lampke, T. Introduction to Plasma Electrolytic Oxidation—An Overview of the Process and Applications. Coatings 2020, 10, 628. [Google Scholar] [CrossRef]
- Aliofkhazraei, M.; Macdonald, D.; Matykina, E.; Parfenov, E.V.; Egorkin, V.S.; Curran, J.A.; Troughton, S.C.; Sinebryukhov, S.L.; Gnedenkov, S.V.; Lampke, T.; et al. Review of Plasma Electrolytic Oxidation of Titanium Substrates: Mechanism, Properties, Applications and Limitations. Appl. Surf. Sci. Adv. 2021, 5, 100121. [Google Scholar] [CrossRef]
- Theerthagiri, J.; Madhavan, J.; Lee, S.J.; Choi, M.Y.; Ashokkumar, M.; Pollet, B.G. Sonoelectrochemistry for Energy and Environmental Applications. Ultrason. Sonochem. 2020, 63, 104960. [Google Scholar] [CrossRef] [PubMed]
- Costa, J.M.; de Almeida Neto, A.F. Ultrasound-Assisted Electrodeposition and Synthesis of Alloys and Composite Materials: A Review. Ultrason. Sonochem. 2020, 68, 105193. [Google Scholar] [CrossRef]
- Komarova, E.G.; Kazantseva, E.A.; Sedelnikova, M.B.; Sharkeev, Y.P. Influence of Ultrasonic Field during Micro-Arc Oxidation on the Structure and Properties of Calcium Phosphate Coatings. J. Phys. Conf. Ser. 2019, 1393, 012098. [Google Scholar] [CrossRef]
- Kazantseva, E.A.; Komarova, E.G.; Sharkeev, Y.P. Effect of Ultrasound during Micro-Arc Oxidation on the Porous Structure and Adhesion Strength of the Calcium Phosphate Coatings. In Proceedings of the International Conference on Advanced Materials with Hierarchical Structure for New Technologies and Reliable Structures 2019, Tomsk, Russia, 1–5 October 2019; p. 020155. [Google Scholar]
- Kazantseva, E.A.; Komarova, E.G.; Sharkeev, Y.P. Structural and Morphological Features of the Ultrasound-Assisted Micro-Arc Oxidation Coatings. In Proceedings of the International Conference on Advanced Materials with Hierarchical Structure for New Technologies and Reliable Structures 2019, Tomsk, Russia, 1–5 October 2019; p. 020156. [Google Scholar]
- Komarova, E.G.; Sharkeev, Y.P.; Sedelnikova, M.B.; Prosolov, K.A.; Khlusov, I.A.; Prymak, O.; Epple, M. Zn- or Cu-Containing CaP-Based Coatings Formed by Micro-Arc Oxidation on Titanium and Ti-40Nb Alloy: Part I—Microstructure, Composition and Properties. Materials 2020, 13, 4116. [Google Scholar] [CrossRef]
- Komarova, E.G.; Sharkeev, Y.P.; Sedelnikova, M.B.; Prymak, O.; Epple, M.; Litvinova, L.S.; Shupletsova, V.V.; Malashchenko, V.V.; Yurova, K.A.; Dzyuman, A.N.; et al. Zn- or Cu-Containing CaP-Based Coatings Formed by Micro-Arc Oxidation on Titanium and Ti-40Nb Alloy: Part II—Wettability and Biological Performance. Materials 2020, 13, 4366. [Google Scholar] [CrossRef]
- Chaikina, M.V.; Bulina, N.V.; Vinokurova, O.B.; Prosanov, I.Y.; Dudina, D.V. Interaction of Calcium Phosphates with Calcium Oxide or Calcium Hydroxide during the “Soft” Mechanochemical Synthesis of Hydroxyapatite. Ceram. Int. 2019, 45, 16927–16933. [Google Scholar] [CrossRef]
- Bulina, N.V.; Vinokurova, O.B.; Eremina, N.V.; Prosanov, I.Y.; Khusnutdinov, V.R.; Chaikina, M.V. Features of Solid-Phase Mechanochemical Synthesis of Hydroxyapatite Doped by Copper and Zinc Ions. J. Solid State Chem. 2021, 296, 121973. [Google Scholar] [CrossRef]
- Sedelnikova, M.B.; Komarova, E.G.; Sharkeev, Y.P.; Chebodaeva, V.V.; Tolkacheva, T.V.; Kondranova, A.M.; Zakharenko, A.M.; Bakina, O.V. Effect of the Porosity, Roughness, Wettability, and Charge of Micro-Arc Coatings on the Efficiency of Doxorubicin Delivery and Suppression of Cancer Cells. Coatings 2020, 10, 664. [Google Scholar] [CrossRef]
- Zarrin, A.; Foroozesh, M.; Hamidi, M.; Mohammadisamani, S. A Simple and Rapid HPLC Method for Quantitation of Interferon-A2b in Dosage Forms and Delivery Systems. J. Chromatogr. B 2006, 833, 199–203. [Google Scholar] [CrossRef] [PubMed]
- Goodman, S. Tools of the Cell Biologist. In Medical Cell Biology; Elsevier: Amsterdam, The Netherlands, 2008; pp. 1–26. ISBN 978-0-12-370458-0. [Google Scholar]
- Bauer, A.W.; Kirby, W.M.M.; Sherris, J.C.; Turck, M. Antibiotic Susceptibility Testing by a Standardized Single Disk Method. Am. J. Clin. Pathol. 1966, 45, 493–496. [Google Scholar] [CrossRef] [PubMed]
- Newbury, D.E.; Ritchie, N.W.M. Performing Elemental Microanalysis with High Accuracy and High Precision by Scanning Electron Microscopy/Silicon Drift Detector Energy-Dispersive X-ray Spectrometry (SEM/SDD-EDS). J. Mater. Sci. 2015, 50, 493–518. [Google Scholar] [CrossRef] [PubMed]
- Komarova, E.G.; Chebodaeva, V.V.; Khlusov, I.A.; Sharkeev, Y.P. Elemental Composition and Distribution in the Micro-Arc Calcium Phosphate Coatings. In Proceedings of the International Conference on Physical Mesomechanics. Materials with Multilevel Hierarchical Structure and Intelligent Manufacturing Technology, Tomsk, Russia, 5–9 October 2020; p. 020154. [Google Scholar]
- Shahrezaee, M.; Raz, M.; Shishehbor, S.; Moztarzadeh, F.; Baghbani, F.; Sadeghi, A.; Bajelani, K.; Tondnevis, F. Synthesis of Magnesium Doped Amorphous Calcium Phosphate as a Bioceramic for Biomedical Application: In Vitro Study. Silicon 2018, 10, 1171–1179. [Google Scholar] [CrossRef]
- El Hazzat, M.; El Hamidi, A.; Halim, M.; Arsalane, S. Complex Evolution of Phase during the Thermal Investigation of Brushite-Type Calcium Phosphate CaHPO4·2H2O. Materialia 2021, 16, 101055. [Google Scholar] [CrossRef]
- Salimi, E.; Javadpour, J. Synthesis and Characterization of Nanoporous Monetite Which Can Be Applicable for Drug Carrier. J. Nanomater. 2012, 2012, 135. [Google Scholar] [CrossRef]
- Mohamed, H.B.; El-Shanawany, S.M.; Hamad, M.A.; Elsabahy, M. Niosomes: A Strategy toward Prevention of Clinically Significant Drug Incompatibilities. Sci. Rep. 2017, 7, 6340. [Google Scholar] [CrossRef]
- Sun, J.; Li, J.; Fan, H.; Ai, S. Ag Nanoparticles and Vancomycin Comodified Layered Double Hydroxides for Simultaneous Capture and Disinfection of Bacteria. J. Mater. Chem. B 2013, 1, 5436. [Google Scholar] [CrossRef]
- Cama, G.; Gharibi, B.; Knowles, J.C.; Romeed, S.; DiSilvio, L.; Deb, S. Structural Changes and Biological Responsiveness of an Injectable and Mouldable Monetite Bone Graft Generated by a Facile Synthetic Method. J. R. Soc. Interface 2014, 11, 20140727. [Google Scholar] [CrossRef]
- Hou, S.; Ma, H.; Ji, Y.; Hou, W.; Jia, N. A Calcium Phosphate Nanoparticle-Based Biocarrier for Efficient Cellular Delivery of Antisense Oligodeoxynucleotides. ACS Appl. Mater. Interfaces 2013, 5, 1131–1136. [Google Scholar] [CrossRef]
- Anthony Evans, E. Biologic therapy of cancer. Editors V T DeVita (Jr), S Hellman and S A Rosenberg Pub: J B Lippincott company, Philadelphia, USA, 1991, pp 816 price: US $125.00 ISBN 0-397-51027-6. J. Label. Compd. Radiopharm. 1992, 31, 79–80. [Google Scholar] [CrossRef]
- Zeng, Y.; Hoque, J.; Varghese, S. Biomaterial-Assisted Local and Systemic Delivery of Bioactive Agents for Bone Repair. Acta Biomater. 2019, 93, 152–168. [Google Scholar] [CrossRef] [PubMed]
- Radin, S.; Campbell, J.T.; Ducheyne, P.; Cuckler, J.M. Calcium Phosphate Ceramic Coatings as Carriers of Vancomycin. Biomaterials 1997, 18, 777–782. [Google Scholar] [CrossRef]
- Tan, R.; She, Z.; Wang, M.; Yu, X.; Jin, H.; Feng, Q. Repair of Rat Calvarial Bone Defects by Controlled Release of RhBMP-2 from an Injectable Bone Regeneration Composite: Repair of Rat Calvarial Bone Defects by Controlled Release of RhBMP-2. J. Tissue Eng. Regen. Med. 2012, 6, 614–621. [Google Scholar] [CrossRef] [PubMed]
- Kim, H.-W.; Knowles, J.C.; Kim, H.-E. Hydroxyapatite/Poly(ε-Caprolactone) Composite Coatings on Hydroxyapatite Porous Bone Scaffold for Drug Delivery. Biomaterials 2004, 25, 1279–1287. [Google Scholar] [CrossRef]
- Luo, S.; Jiang, T.; Long, L.; Yang, Y.; Yang, X.; Luo, L.; Li, J.; Chen, Z.; Zou, C.; Luo, S. A Dual PMMA/Calcium Sulfate Carrier of Vancomycin Is More Effective than PMMA-vancomycin at Inhibiting Staphylococcus aureus Growth in vitro. FEBS Open Bio 2020, 10, 552–560. [Google Scholar] [CrossRef]
- Sedelnikova, M.B.; Komarova, E.G.; Sharkeev, Y.P.; Ugodchikova, A.V.; Mushtovatova, L.S.; Karpova, M.R.; Sheikin, V.V.; Litvinova, L.S.; Khlusov, I.A. Zn-, Cu- or Ag-Incorporated Micro-Arc Coatings on Titanium Alloys: Properties and Behavior in Synthetic Biological Media. Surf. Coat. Technol. 2019, 369, 52–68. [Google Scholar] [CrossRef]
- Uskoković, V.; Batarni, S.S.; Schweicher, J.; King, A.; Desai, T.A. Effect of Calcium Phosphate Particle Shape and Size on Their Antibacterial and Osteogenic Activity in the Delivery of Antibiotics in Vitro. ACS Appl. Mater. Interfaces 2013, 5, 2422–2431. [Google Scholar] [CrossRef]
- Khlusov, I.A.; Kibler, E.V.; Kudryavtseva, V.L.; Tverdokhlebov, S.I.; Bolbasov, E.N.; Botvin, V.V.; Latypov, A.D.; Gazatova, N.D.; Litvinova, L.S.; Buznik, V.M.; et al. Electrospray Preparation of Biocompatible Lactide–Glycolide Copolymer Capsules with Incorporation of Interferon. Dokl. Chem. 2019, 484, 74–78. [Google Scholar] [CrossRef]
- Grela, E.; Kozłowska, J.; Grabowiecka, A. Current Methodology of MTT Assay in Bacteria—A Review. Acta Histochem. 2018, 120, 303–311. [Google Scholar] [CrossRef]
- Tite, T.; Popa, A.-C.; Balescu, L.; Bogdan, I.; Pasuk, I.; Ferreira, J.; Stan, G. Cationic Substitutions in Hydroxyapatite: Current Status of the Derived Biofunctional Effects and Their In Vitro Interrogation Methods. Materials 2018, 11, 2081. [Google Scholar] [CrossRef] [PubMed]
- Ghasemi, M.; Turnbull, T.; Sebastian, S.; Kempson, I. The MTT Assay: Utility, Limitations, Pitfalls, and Interpretation in Bulk and Single-Cell Analysis. Int. J. Mol. Sci. 2021, 22, 12827. [Google Scholar] [CrossRef] [PubMed]
- Karakaş, D.; Ari, F.; Ulukaya, E. The MTT Viability Assay Yields Strikingly False-Positive Viabilities Although the Cells Are Killed by Some Plant Extracts. Turk. J. Biol. 2017, 41, 919–925. [Google Scholar] [CrossRef]
- Majidinia, M.; Sadeghpour, A.; Yousefi, B. The Roles of Signaling Pathways in Bone Repair and Regeneration. J. Cell. Physiol. 2018, 233, 2937–2948. [Google Scholar] [CrossRef] [PubMed]
- Sareen, D.; Darjatmoko, S.R.; Albert, D.M.; Polans, A.S. Mitochondria, Calcium, and Calpain Are Key Mediators of Resveratrol-Induced Apoptosis in Breast Cancer. Mol. Pharmacol. 2007, 72, 1466–1475. [Google Scholar] [CrossRef] [PubMed]
- Rapa, S.F.; Magliocca, G.; Pepe, G.; Amodio, G.; Autore, G.; Campiglia, P.; Marzocco, S. Protective Effect of Pomegranate on Oxidative Stress and Inflammatory Response Induced by 5-Fluorouracil in Human Keratinocytes. Antioxidants 2021, 10, 203. [Google Scholar] [CrossRef]
- García, M.A.; Marchal, J.A.; Carrasco, E.; Ramirez, A.; Jimenez, G.; Olmedo, C.; Peran, M.; Agil, A.; Conejo-Garcia, A.; Cruz-Lopez, O.; et al. Bozepinib, a Novel Small Antitumor Agent, Induces PKR-Mediated Apoptosis and Synergizes with IFNα Triggering Apoptosis, Autophagy and Senescence. Drug Des. Dev. Ther. 2013, 7, 1301–1313. [Google Scholar] [CrossRef][Green Version]
- Numaguchi, S.; Okuno, M.; Moriwaki, H.; Muto, Y. Modulation of Collagen Synthesis and Degradation by Retinoids and Cytokines in 3T3 L1 Preadipocytes. Intern. Med. 1994, 33, 309–316. [Google Scholar] [CrossRef][Green Version]
- Jauharoh, S.N.A.; Saegusa, J.; Sugimoto, T.; Ardianto, B.; Kasagi, S.; Sugiyama, D.; Kurimoto, C.; Tokuno, O.; Nakamachi, Y.; Kumagai, S.; et al. SS-A/Ro52 Promotes Apoptosis by Regulating Bcl-2 Production. Biochem. Biophys. Res. Commun. 2012, 417, 582–587. [Google Scholar] [CrossRef]
- Gastl, G.; Marth, C.; Leiter, C.; Gattringer, C.; Mayer, I.; Daxenbichler, G.; Flener, R.; Huber, C. Effects of Human Recombinant Alpha 2 Arg-Interferon and Gamma-Interferon on Human Breast Cancer Cell Lines: Dissociation of Antiproliferative Activity and Induction of HLA-DR Antigen Expression. Cancer Res. 1985, 7, 2957–2961. [Google Scholar]
- Ruiz-Ruiz, C.; López-Rivas, A. Mitochondria-Dependent and -Independent Mechanisms in Tumour Necrosis Factor-Related Apoptosis-Inducing Ligand (TRAIL)-Induced Apoptosis Are Both Regulated by Interferon-γ in Human Breast Tumour Cells. Biochem. J. 2002, 365, 825–832. [Google Scholar] [CrossRef]
- Kazakov, A.S.; Mayorov, S.A.; Deryusheva, E.I.; Avkhacheva, N.V.; Denessiouk, K.A.; Denesyuk, A.I.; Rastrygina, V.A.; Permyakov, E.A.; Permyakov, S.E. Highly Specific Interaction of Monomeric S100P Protein with Interferon Beta. Int. J. Biol. Macromol. 2020, 143, 633–639. [Google Scholar] [CrossRef] [PubMed]
- Li, Q.; Tang, L.; Roberts, P.C.; Kraniak, J.M.; Fridman, A.L.; Kulaeva, O.I.; Tehrani, O.S.; Tainsky, M.A. Interferon Regulatory Factors IRF5 and IRF7 Inhibit Growth and Induce Senescence in Immortal Li-Fraumeni Fibroblasts. Mol. Cancer Res. 2008, 6, 770–784. [Google Scholar] [CrossRef] [PubMed]
- Sergeev, I.N. Calcium Signaling in Cancer and Vitamin D. J. Steroid Biochem. Mol. Biol. 2005, 97, 145–151. [Google Scholar] [CrossRef] [PubMed]
- Kronvall, G.; Ringertz, S. Antibiotic Disk Diffusion Testing Revisited. Single Strain Regression Analysis. APMIS 1991, 99, 295–306. [Google Scholar] [CrossRef]
- Schnieders, J.; Gbureck, U.; Vorndran, E.; Schossig, M.; Kissel, T. The Effect of Porosity on Drug Release Kinetics from Vancomycin Microsphere/Calcium Phosphate Cement Composites. J. Biomed. Mater. Res. B 2011, 99, 391–398. [Google Scholar] [CrossRef]
- Cao, Z.; Jiang, D.; Yan, L.; Wu, J. In Vitro and in Vivo Drug Release and Antibacterial Properties of the Novel Vancomycin-Loaded Bone-like Hydroxyapatite/Poly Amino Acid Scaffold. Int. J. Nanomed. 2017, 2071, 1841–1851. [Google Scholar] [CrossRef]
- Polo, L.; Díaz de Greñu, B.; Della Bella, E.; Pagani, S.; Torricelli, P.; Vivancos, J.L.; Ruiz-Rico, M.; Barat, J.M.; Aznar, E.; Martínez-Máñez, R.; et al. Antimicrobial Activity of Commercial Calcium Phosphate Based Materials Functionalized with Vanillin. Acta Biomater. 2018, 81, 293–303. [Google Scholar] [CrossRef]
- Wu, V.M.; Tang, S.; Uskoković, V. Calcium Phosphate Nanoparticles as Intrinsic Inorganic Antimicrobials: The Antibacterial Effect. ACS Appl. Mater. Interfaces 2018, 10, 34013–34028. [Google Scholar] [CrossRef]
- Karlov, A.V.; Khlusov, I.A.; Pontak, V.A.; Ignatov, V.P.; Ivin, M.A.; Zinatulina, S.Y. Adhesion of Staphylococcus Aureus to Implants with Different Physicochemical Characteristics. Bull. Exp. Biol. Med. 2002, 134, 277–280. [Google Scholar] [CrossRef]

| Extraction Time, h | IFNα Amounts in Extracts, pg and % of Release Compared with Initial Content of 101,904 pg per Sample |
|---|---|
| 1 | 13,790 (12,750–14,850) 13.5 (12.5–14.6)% |
| 6 | 7250 (6100–8280) 7.1 (6.0–8.1)% |
| 12 | 15,460 (14,960–15,950) 15.2 (14.7–15.7)% |
| 24 | 8350 (6440–16,670) 8.2 (6.3–16.4)% |
| 48 | 3100 (2750–3490) 3.0 (2.7–3.4)% |
| No. | Sample Group | Width of t S. aureus Inhibition Zone (H) for Different Time Points, mm | |||||
|---|---|---|---|---|---|---|---|
| n = 3 | 1 h | 6 h | 24 h | 48 h | 96 h | 120 h | |
| 1 | UMAOHCaP (VMN 50 mg/mL) | 0.9 (0–1.1) a,b | 1.8 (1.4–2) a,b | 3.2 (2.8–3.3) a,b | 2.1 (2.1–2.7) a,b | 1 (1–1.3) a,b | 0 b |
| 2 | UMAOHCaP (VMN 25 mg/mL) | 0.3 (0.1–1) a,b | 1 (0.9–1.1) a,b | 1.5 (1.4–2) a,b | 1 (0.1–1.2) a,b | 0.8 (0.3–1) b | 0 b |
| pT1 < 0.05 | |||||||
| 3 | UMAOHCaP (VMN 10 mg/mL) | 0.1 (0–0.1)a,b | 0.3 (0.3–0.9) a,b | 0.1 (0.1–0.1) b | 0.1 (0–0.2)b | 0.2 (0.1–0.3) b | 0 b |
| pT1,2 < 0.05 | |||||||
| 4 | VMN 20 µg/mL (Positive control of bactericidal action) | 7.2 (7.2–8.9) | 9.2 (7.1–9.5) | 9.3 (8.6–9.8) | 8.4 (8–8.5) | 8.4 (7.4–8.9) | 8.6 (7.8–8.6) |
| 5 | UMAOH CaP (Negative control of bactericidal action) | 0 b | 0 b | 0 (0–0.1) b | 0 (0–0.4) b | 0.4 (0.1–0.7) b | 0b |
Publisher’s Note: MDPI stays neutral with regard to jurisdictional claims in published maps and institutional affiliations. |
© 2022 by the authors. Licensee MDPI, Basel, Switzerland. This article is an open access article distributed under the terms and conditions of the Creative Commons Attribution (CC BY) license (https://creativecommons.org/licenses/by/4.0/).
Share and Cite
Prosolov, K.A.; Komarova, E.G.; Kazantseva, E.A.; Lozhkomoev, A.S.; Kazantsev, S.O.; Bakina, O.V.; Mishina, M.V.; Zima, A.P.; Krivoshchekov, S.V.; Khlusov, I.A.; et al. UMAOH Calcium Phosphate Coatings Designed for Drug Delivery: Vancomycin, 5-Fluorouracil, Interferon α-2b Case. Materials 2022, 15, 4643. https://doi.org/10.3390/ma15134643
Prosolov KA, Komarova EG, Kazantseva EA, Lozhkomoev AS, Kazantsev SO, Bakina OV, Mishina MV, Zima AP, Krivoshchekov SV, Khlusov IA, et al. UMAOH Calcium Phosphate Coatings Designed for Drug Delivery: Vancomycin, 5-Fluorouracil, Interferon α-2b Case. Materials. 2022; 15(13):4643. https://doi.org/10.3390/ma15134643
Chicago/Turabian StyleProsolov, Konstantin A., Ekaterina G. Komarova, Ekaterina A. Kazantseva, Aleksandr S. Lozhkomoev, Sergei O. Kazantsev, Olga V. Bakina, Marina V. Mishina, Anastasia P. Zima, Sergei V. Krivoshchekov, Igor A. Khlusov, and et al. 2022. "UMAOH Calcium Phosphate Coatings Designed for Drug Delivery: Vancomycin, 5-Fluorouracil, Interferon α-2b Case" Materials 15, no. 13: 4643. https://doi.org/10.3390/ma15134643
APA StyleProsolov, K. A., Komarova, E. G., Kazantseva, E. A., Lozhkomoev, A. S., Kazantsev, S. O., Bakina, O. V., Mishina, M. V., Zima, A. P., Krivoshchekov, S. V., Khlusov, I. A., & Sharkeev, Y. P. (2022). UMAOH Calcium Phosphate Coatings Designed for Drug Delivery: Vancomycin, 5-Fluorouracil, Interferon α-2b Case. Materials, 15(13), 4643. https://doi.org/10.3390/ma15134643

